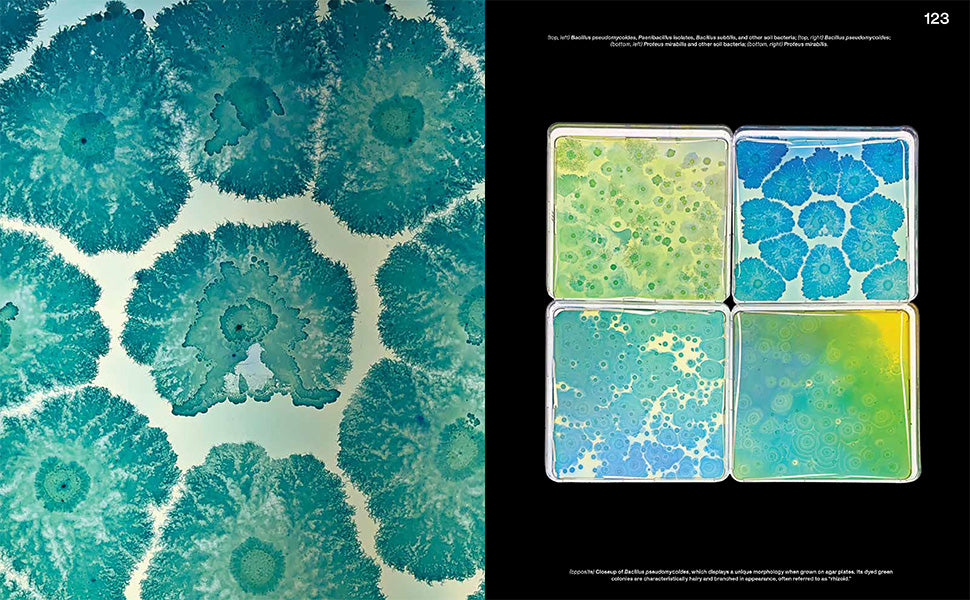
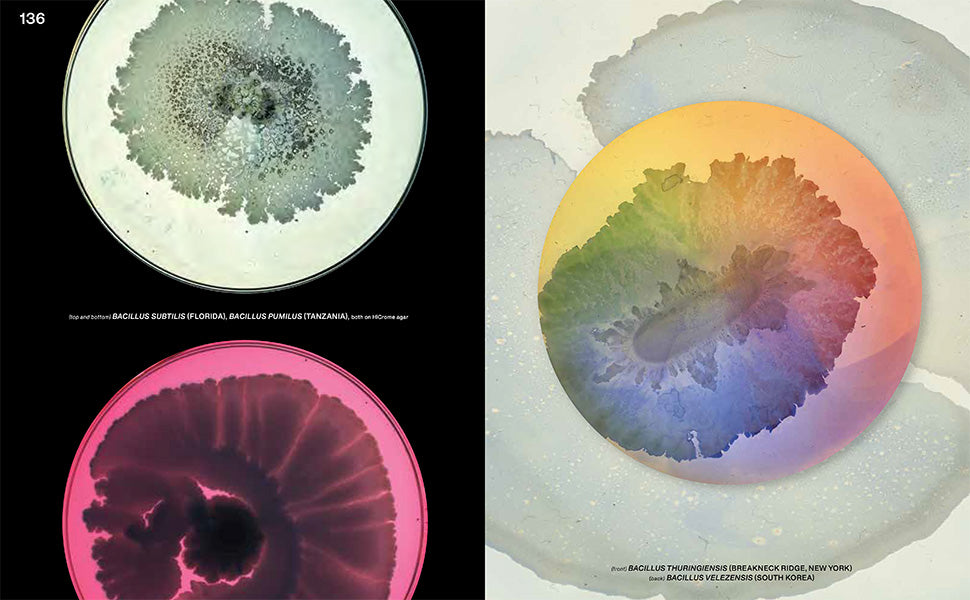

Beautiful Bacteria
Free Shipping
Economy shipping is FREE for all orders over $139, within the contiguous United States (lower 48 states).
Free Returns
If you are not 100% satisfied with your purchase for any reason, just contact us and we'll be happy to provide a FREE pre-paid return label for any order shipped within the contiguous United States (lower 48 states).
Return your order to us within 30 days and we’ll process a full refund. Please note premium (non-economy) shipping fees are non-refundable. You can review our full return policy here.
This visually striking volume combines stunning imagery with engaging narratives, illuminating the intricate lives of bacteria we encounter daily. Each chapter presents a unique type of bacteria, showcasing magnificent photographs that reveal their hidden beauty while providing accessible explanations of their roles in our lives.
Beautiful Bacteria unravels the secrets of the microscopic world that shapes our existence. Discover the origins, functions, and groundbreaking advancements in biotechnology that stem from these tiny organisms. From the intricate patterns of Proteus mirabilis to the mesmerizing forms of E. coli, this book invites readers to ponder profound questions about life itself.
Details
Dimensions
W 8 x L 10 x D 0.8 inWeight
2.14 lbPage Count
184Printed in
ChinaReleased On
3/26/24Format
HardcoverISBN
9780847899869Published By
Rizzoli ElectaShipping & Returns
Orders over $139 ship free. Find out more about our shipping options.
Free returns on all orders within 30 days. Find out more about our returns policy.
Choose options

★★★★★
I'm obsessed with my books from Blank Canvas Bookstore. By far the best way to spend a lazy weekend!!
Ashley C.
★★★★★
Blank Canvas Bookstore is great. I love the crazier colors.
Laura A.
★★★★☆
I unfortunately had an issue with my order.... but the person who resolved it was so helpful and nice!
Elizabeth B.
